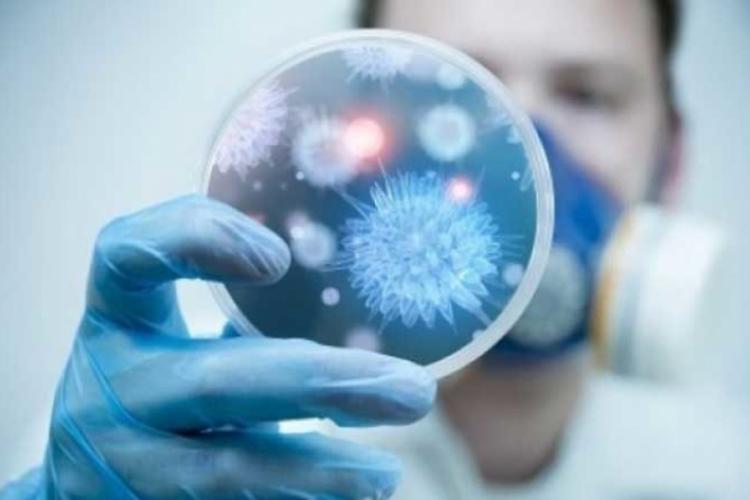

SĂNĂTATE
Infecţiile intraspitaliceşti se dublează!
• numai în primele 4 luni ale acestui an, spitalele din întreaga ţară au raportat peste 1.000 de cazuri, dintre care la Brăila figurează, oficial, 98 •cele mai multe infecţii raportate au fost cu Clostridium difficile, o infecţie cu o incidenţă mare, care apare în mediul spitalicesc în relaţie directă cu tratamentul pe bază de antibiotice şi care necesită măsuri speciale de izolare, din cauza gradului mare de contagiozitate
Spitalul Judeţean de Urgenţă (SJU) Brăila şi alte 68 de spitale din întreaga ţară, au raportat în 2019, peste 1.000 de infecţii nosocomiale sau infecţii asociate asistenţei medicale, cum se numesc după noul Ordin de Ministru din 7 octombrie 2016. Potrivit Autorităţii Naţionale de Management al Calităţii în Sănătate (IAAM), asta înseamnă că, numărul acestor infecţii recunoscute şi raportate, aproape s-a dublat, faţă de aceeaşi perioadă a anului 2018 şi evidenţiază preocuparea tot mai mare a unităţilor sanitare în recunoaşterea şi anunţarea lor pentru a putea fi gestionate corect.
Numai la Brăila, în primele 4 luni ale acestui an, au fost raportate 98 de cazuri cu infecţii nosocomiale în unităţile spitaliceşti din municipiul Brăila. Ca în fiecare an, cele mai multe au fost raportate de Spitalul Judeţean de Urgenţă Brăila, de altfel, şi cel mai mare spital din întreg judeţul, unde figurează, oficial, 90 de infecţii asociate asistenţei medicale. “ La Spitalul Judeţean de Urgenţă Brăila, în luna ianuarie au fost raportate 23 de cazuri, în februarie sunt 29, în martie 17 şi în aprilie sunt 21. Restul, au mai fost raportate la Spitalul de Paleaţie-3, la Spitalul de Pneumoftiziologie-3 cazuri şi la Spitalul de Psihiatrie-2 cazuri “, a informat directorul Direcţiei de Sănătate Publică (DSP) Brăila, dr. Gabriel Ciochină. Astfel, la Brăila, la fel ca în mai toată ţara, raportarea infecţiilor nosocomiale arată o tendinţă de creştere, faţă de anii trecuţi. De exemplu, în 2018, au fost raportate la ANMCS, în total, 2.274 de infecţii de către 110 spitale, iar Spitalul Judeţean de Urgenţă Brăila este unul dintre ele. Numai aici au fost raportate, în primele 7 luni din 2018, 108 infecţii asociate asistenţei medicale, dintr-un total de 118, cât s-a raportat la nivelul întregului judeţ. Ca o medie, am spune că lunar, la SJU Brăila, au fost raportate în jur de 20 de cazuri, un număr relativ mare dacă ne uităm la cifrele din 2012, de exemplu, când la Brăila abia dacă se raportau, pe întreg judeţul, 24 de cazuri, sau în 2013 când figurau oficial doar 13 infecţii nosocomiale, sau în 2014 când au fost raportate 36, în 2015 – 44 şi în 2016- 75. Situaţia s-a schimbat brusc, însă, după tragedia din clubul Colectiv, când mai mulţi tineri au murit din cauza complicaţiilor apărute din cauza infecţiilor din spitalele din România, în timp ce alţii au reuşit să supravieţuiască şi s-au recuperat parţial. Atunci, un nou Ordin de Ministru, cu număr de înregistrare 1.101 avea să schimbe nu doar denumirea infecţiilor nosocomiale în infecţii asociate asistenţei medicale, dar să schimbe ceva şi în mentalitatea responsabililor din unităţile spitaliceşti din România. Un fenomen care s-a observat, de altfel, şi la Brăila, în 2017, când spitalele au raportat 131 de cazuri de infecţii intraspitaliceşti. Cifre care nu reflectă, neapărat, realitatea, cât mai ales un control mai mare asupra răspândirii germenilor, spune directorul DSP Brăila. “Da sunt mai multe cazuri raportate faţă de anii trecuţi, dar asta nu înseamnă că e de rău, neapărat. Tendinţa e bună pentru că sunt mai multe infecţii raportate, pentru că aşa cum se ştie, ani de zile România stătea foarte bine la acest capitol, erau două cazuri de infecţii intraspitaliceşti sau, mă rog, foarte puţine raportate. În momentul de faţă, vorbim de o normalitate, din punctul meu de vedere”, a mai precizat conducerea DSP Brăila, dr. Gabriel Ciochină.
În ceea ce priveşte flora bacteriană responsabilă de cele mai multe cazuri de infecţii intraspitaliceşti, la Brăila, la fel ca în mai toate spitalele din România, a predominat infecţia cu Clostridium difficile. Potrivit specialiştilor, infecţia cu Clostridium difficile este o infecţie cu o incidenţă mare, care apare în mediul spitalicesc în relaţie directă cu tratamentul pe bază de antibiotice şi care necesită măsuri speciale de izolare, din cauza gradului mare de contagiozitate.
Potrivit legii 185/ 2017 privind asigurarea calităţii în sistemul de sănătate, raportarea efectelor adverse asociate asistenţei medicale nu are caracter acuzator. Scopul raportării este de a facilita evaluarea riscului infecţios la internare şi de a identifca cauzele pricipale ale apariţiei acestor evenimente indezirabile asociate asistenţei medicale pentru învăţarea din erori.
ARTICOLE CARE V-AR PUTEA INTERESA
DIN ACEEAȘI CATEGORIE
DE ACELAȘI AUTOR







































